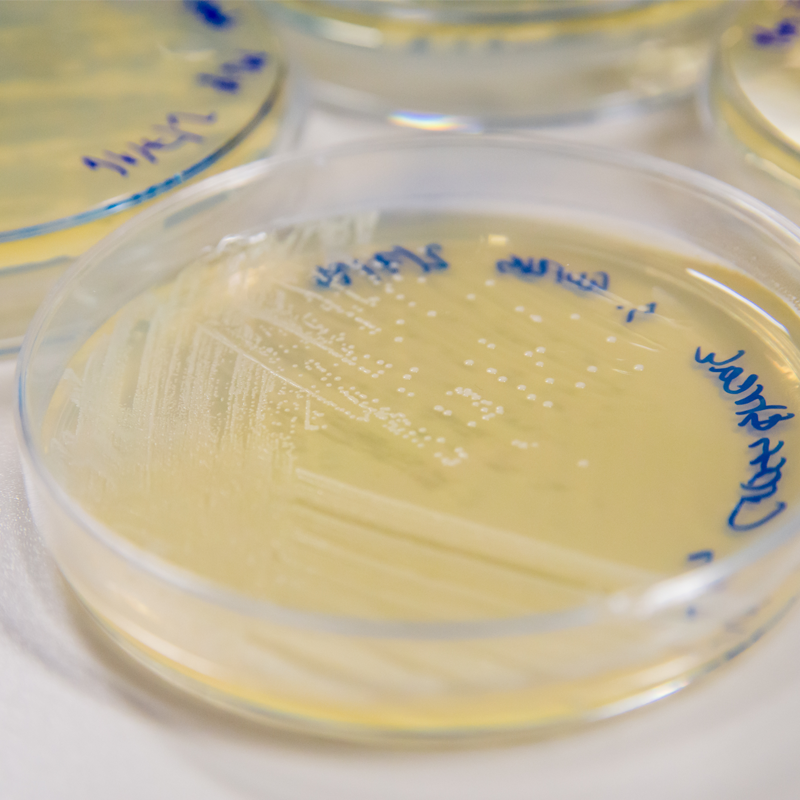
MRSA bacterie in een kweek bakje

GGD Haaglanden wil studenten in Delft informeren over MRSA. In de stad hebben we al sinds 2023 te maken hebben met een klein, maar langdurig cluster van besmettingen. Er is géén sprake van een uitbraak of een gezondheidscrisis.
Voor gezonde mensen is MRSA doorgaans niet gevaarlijk. We willen vooral aandacht vragen voor eenvoudige hygiënemaatregelen om verdere verspreiding te voorkomen. Denk hierbij aan regelmatig handen wassen en het gebruik van je eigen handdoek of scheermesje. Heb je klachten zoals huidinfecties of steenpuisten? Neem dan contact op met je huisarts.
We zien besmettingen onder studenten in meerdere steden in de Randstad, waaronder Delft. Het gaat hierbij om kleine aantallen. Door bewustwording en preventie willen we verdere besmettingen voorkomen.
Wat is MRSA?
MRSA is een bacterie die op de huid of in de neus kan zitten. Meestal merkt u daar niets van. Dan bent u drager van de bacterie. U kunt de bacterie vanzelf weer kwijtraken.
Soms veroorzaakt MRSA een infectie van de huid. U kunt de volgende klachten krijgen:
- roodheid, zwelling of pijn;
- steenpuisten;
- wondjes met pus;
- abcessen (met pus gevulde bulten).
MRSA is moeilijk te behandelen, omdat gewone antibiotica vaak niet werken.
Hoe raakt u besmet met MRSA?
U kunt MRSA krijgen door:
- huid-op-huidcontact, bijvoorbeeld bij sporten of knuffelen;
- contact met besmette spullen, zoals handdoeken of sportmatten;
- contact met wondvocht of huidschilfers van iemand met MRSA.
Hoe voorkomt u besmetting?
- Was uw handen vaak met water en zeep.
- Gebruik uw eigen handdoek, kleding en scheermesje.
- Dek wondjes goed af met een pleister of verband.
- Maak gedeelde spullen schoon, zoals sporttoestellen of deurklinken.
Wanneer moet u zich laten testen op MRSA?
Laat u testen als u:
- klachten heeft zoals hierboven genoemd;
- een huidinfectie heeft die niet beter wordt met antibiotica;
- in de zorg werkt en nauw contact heeft gehad met iemand met MRSA.
Bel dan uw huisarts en zeg dat er MRSA is onder studenten. Vraag om een test (kweek) van de wond of huid.
Heeft u klachten van een huidinfectie?
Als u klachten heeft van een huidinfectie, doe dan niet mee aan groepsactiviteiten waarbij:
- er huid-op-huidcontact is met anderen;
- de huid beschadigd kan raken;
- wondvocht op gedeelde plekken kan komen.
Voorkom verspreiding naar de zorg
Heeft u MRSA en heeft u nauw contact (gehad) met iemand die in de zorg werkt of stage loopt? Bijvoorbeeld een huisgenoot of partner?
Doe dan het volgende:
- vertel die persoon dat u MRSA hebt;
- adviseer hem of haar om bij klachten naar de huisarts te gaan;
- zorgmedewerkers moeten dit melden bij hun bedrijfsarts.